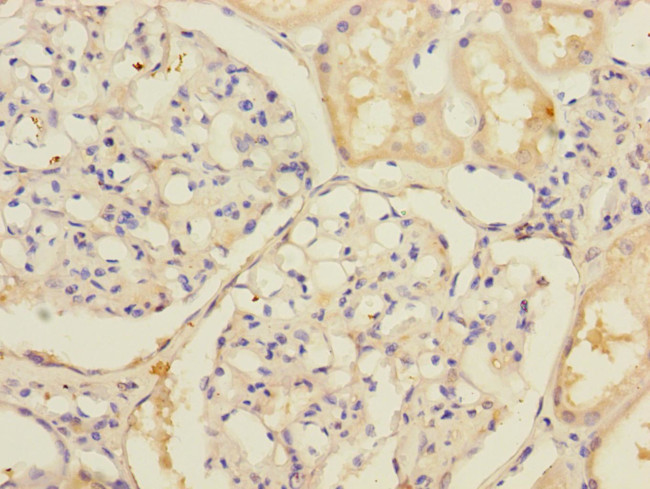
SLC39A7 Antibody in Immunohistochemistry (Paraffin) (IHC (P))

Search
Invitrogen
SLC39A7 Polyclonal Antibody
{{$productOrderCtrl.translations['antibody.pdp.commerceCard.promotion.promotions']}}
{{$productOrderCtrl.translations['antibody.pdp.commerceCard.promotion.viewpromo']}}
{{$productOrderCtrl.translations['antibody.pdp.commerceCard.promotion.promocode']}}: {{promo.promoCode}} {{promo.promoTitle}} {{promo.promoDescription}}. {{$productOrderCtrl.translations['antibody.pdp.commerceCard.promotion.learnmore']}}



Please note: We are reviewing Western blot images included in the antibody testing data in our catalog, including those provided by third parties. Unless expressly labeled or annotated as “raw-unedited”, Western blot images included in the antibody testing data in our catalog may have been edited, optimized or otherwise adjusted for presentation.
产品信息
PA5-98652
种属反应
宿主/亚型
分类
类型
抗原
偶联物
形式
浓度
规格
纯化类型
保存液
内含物
保存条件
运输条件
RRID
靶标信息
The zinc transporter ZIP7, also known as SLC39A7, is a member of a family of divalent ion transporters. Zinc is an essential ion for cells and plays significant roles in the growth, development, and differentiation. ZIP7 was initially identified while characterizing genes in the major histocompatibility complex on chromosome 17. ZIP7 mRNA is abundantly and widely expressed and the protein localizes to the Golgi apparatus. It functions to transport intracellular zinc from the Golgi apparatus to the cytoplasm of the cell. ZIP7 expression is expressed by zinc. ZIP7 has been suggested to act a hub for tyrosine kinase activation and may thus be a potential therapeutic target for diseases such as cancer where prevention of tyrosine kinase activation would be advantageous.
仅用于科研。不用于诊断过程。未经明确授权不得转售。
篇参考文献 (0)
生物信息学
蛋白别名: DADB-100D22.3; Histidine-rich membrane protein Ke4; HLA class II region expressed gene KE4; Ke4 gene; Ke4 gene, mouse, human homolog of; Really interesting new gene 5 protein; solute carrier family 39 (zinc transporter), member 7; Solute carrier family 39 member 7; unnamed protein product; zinc transporter 7; Zinc transporter SLC39A7; ZIP7; Zrt-, Irt-like protein 7
基因别名: AGM9; D6S115E; D6S2244E; H2-KE4; HKE4; KE4; RING5; SLC39A7; ZIP7
Entrez Gene ID: (Human) 7922